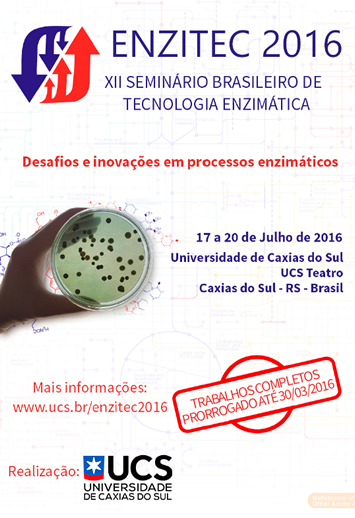

Entre os dias 17 e 20 de julho de 2016, o Rio Grande do Sul receberá o XII Seminário Brasileiro de Tecnologia Enzimática - ENZITEC 2016. A Universidade de Caxias do Sul (UCS) sediará este importante evento científico, em Caxias do Sul.
|
Divulgue o evento. Faça download do cartaz. |
Convidamos a comunidade acadêmica e o setor empresarial a participarem do XII Seminário Brasileiro de Tecnologia Enzimática - ENZITEC 2016 que ocorrerá em Caxias do Sul, RS, no período de 17 a 20 de julho de 2016.
A proposta deste simpósio é promover interação entre cientistas, professores, alunos e profissionais que trabalham com enzimas no Brasil. Tem por objetivo apresentar os últimos avanços das pesquisas realizadas nas Universidades Brasileiras, Institutos e Empresas, em áreas relacionadas a Enzimologia aplicada.
As enzimas são utilizadas em uma extensa gama de setores, incluindo a saúde humana e animal, a indústria química e alimentícia, a agricultura, energia e o saneamento ambiental.
É destacável o papel estratégico que a enzimologia desempenha para o desenvolvimento sustentável. Com a crescente demanda por tecnologias limpas, bem como o interesse pelo uso de recursos renováveis e os desafios da mudança climática global, podemos antever um desenvolvimento ainda mais promissor para utilização de enzimas nos próximos anos, tanto nos setores acima citados como em outros setores.
O Seminário vem sendo realizado a cada dois anos, sendo realizado na sede onde o ENZITEC "nasceu", no Rio de Janeiro e outra vez sendo realizado em outro estado brasileiro, sendo o o ENZITEC o evento de maior importância nesta área de Enzimologia de Brasil e um dos mais importantes mundialmente. De caráter eminentemente científico e tecnológico, busca apresentar avanços científicos e soluções inovadoras às empresas e à sociedade, através da geração de novos processos e produtos enzimáticos, contribuindo assim para o desenvolvimento tecnológico, a geração de emprego, renda e riquezas para o país.
O ENZITEC conta tradicionalmente com a presença de centenas de participantes do Brasil e do exterior, para participar de palestras, minicursos, debates e a apresentação de centenas de trabalhos. A presença de empresas que expõem seus produtos e processos também tem sido uma constante deste evento.
A Universidade de Caxias do Sul, representada pelos Programas de Pós-graduação em Biotecnologia e de Engenharia de Processos e Tecnologias, sente-se honrada em promover o ENZITEC 2016. Este evento, além da arrecadação das inscrições, contará com o suporte financeiro de organismos estaduais e federais de apoio à pesquisa e ao desenvolvimento científico e tecnológico, além de empresas do setor.
Caxias do Sul, a "Pérola das Colônias" é alegre, pujante, hospitaleira, com farta gastronomia, que atrai tanto por seus atributos de metrópole, como pela tradição ítalo-gaúcha e pela beleza de seus encantos rurais. Venha conhecê-la. Ela, seu povo e sua Universidade, terão imensa satisfação e prazer em recebê-lo (a)!
enzitec2016@gmail.com ou (54) 3218-2100 ramal 2681